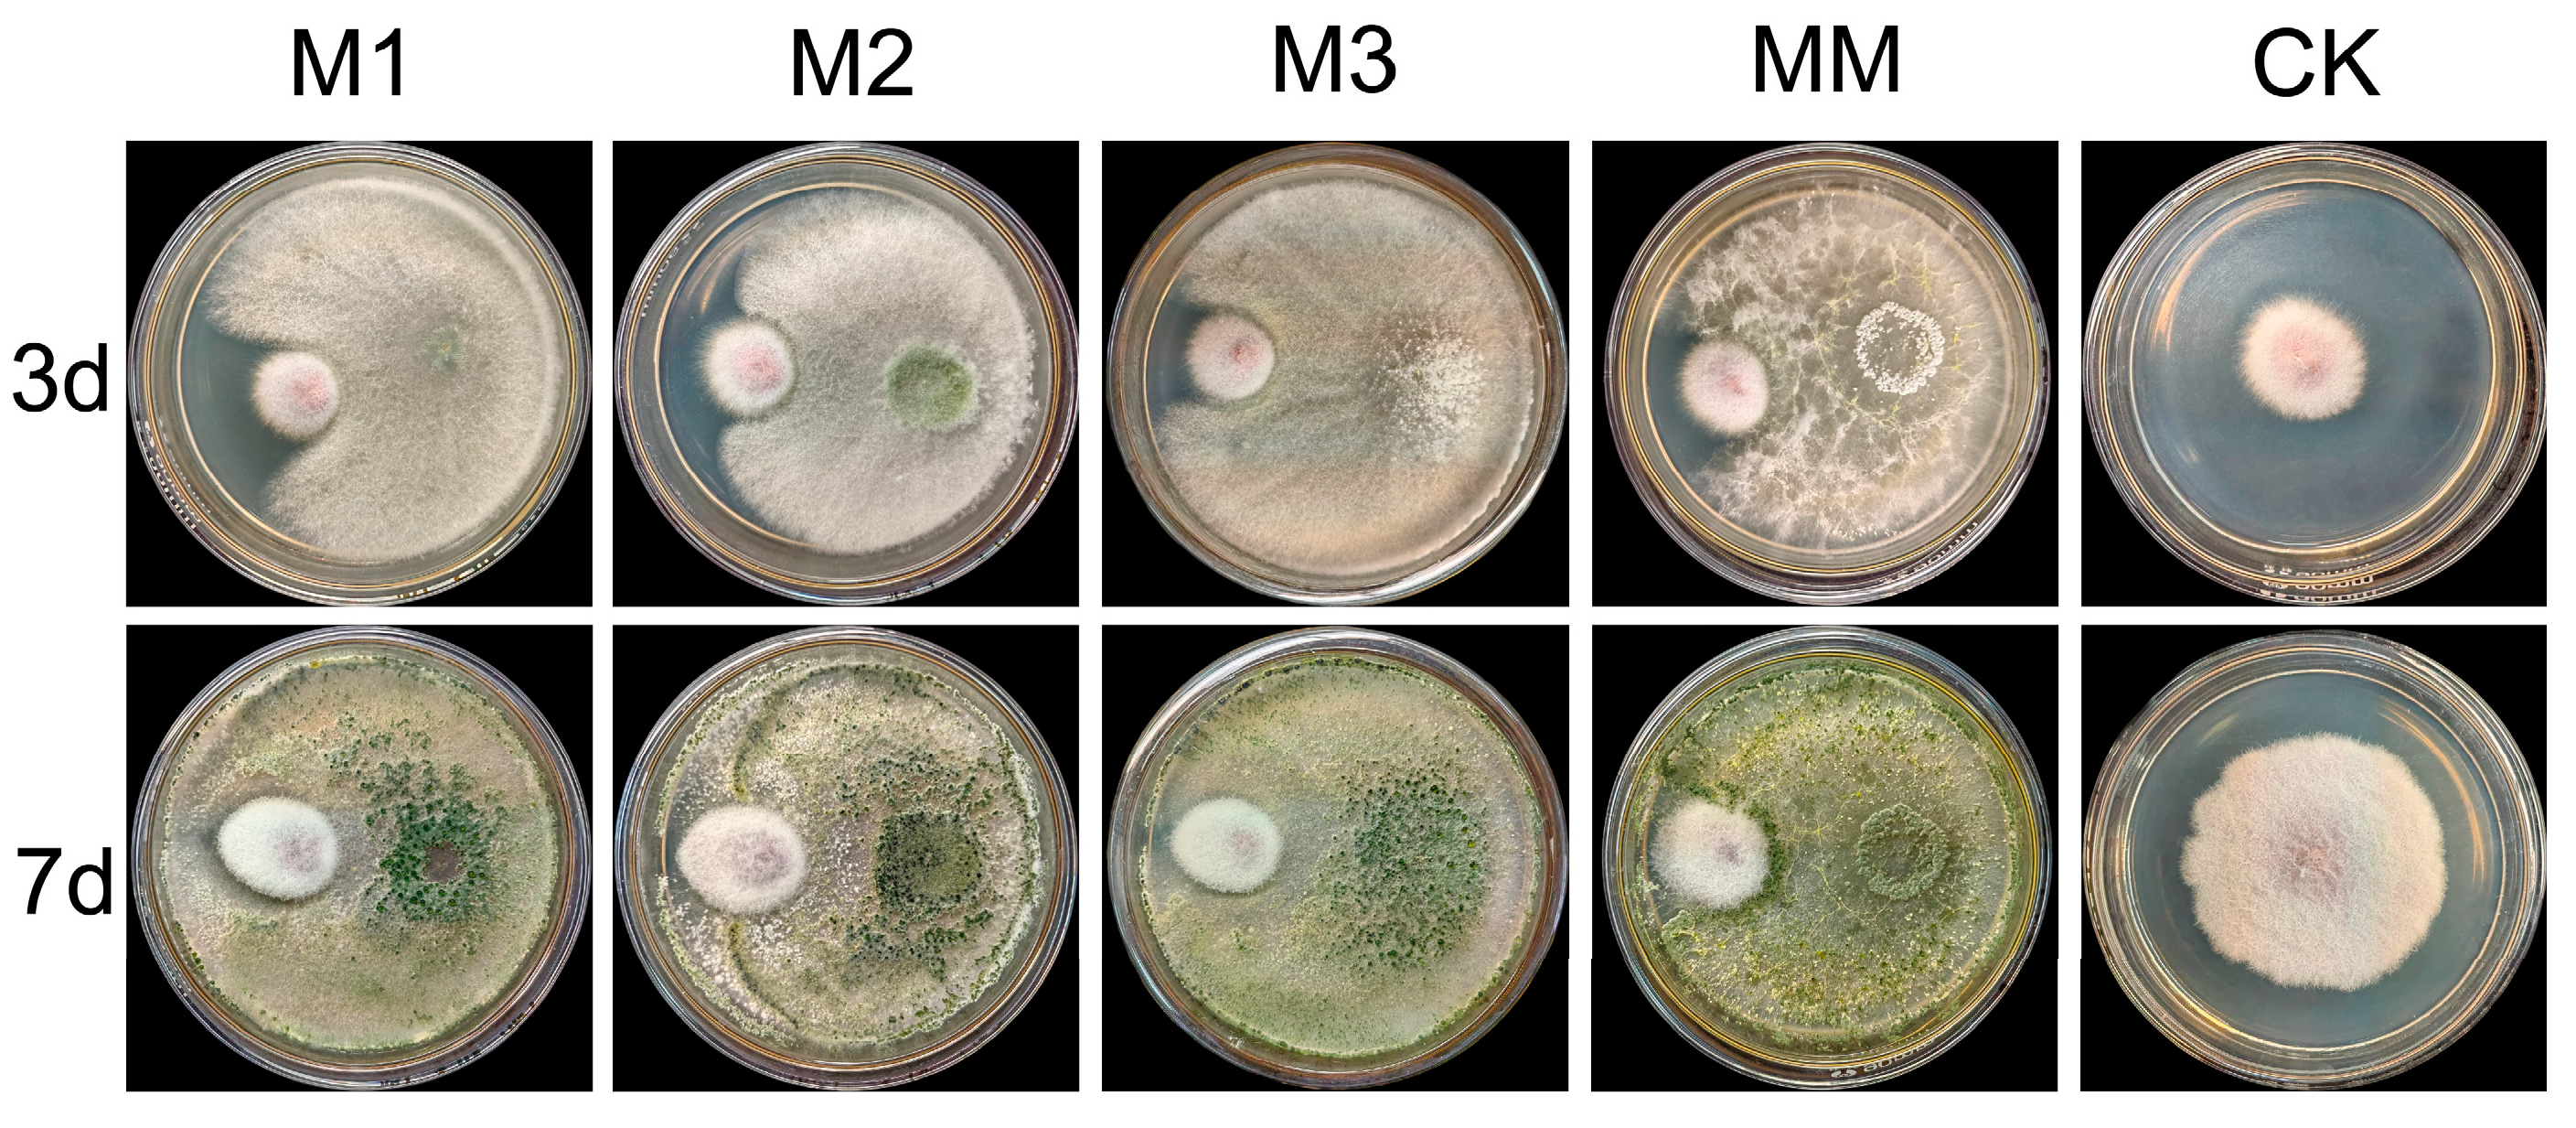
Plants 14 01480 g0a1

First Report of Fusarium proliferatum Infection in Pods of Four-Seeded Vetch and Its Relationships with Plants
Abstract
1. Introduction
2. Results
2.1. Isolation and Pathogenicity Determination of the Pathogenic Fungus
2.2. Morphological Identification
2.3. Phylogenetic Tree Analysis
2.4. Effect of Different Media on the Colony Growth of FVS1 Strain
2.5. Effect of Different Temperatures on the Colony Growth of FVS1 Strain
2.6. Effect of Different Photoperiod on the Colony Growth of FVS1 Strain
2.7. Effect of pH on the Colony Growth of FVS1 Strain
2.8. Metabolomic Profiling of Four-Seeded Vetch-FVS1 Interactions
2.9. Screening Results of Biocontrol Fungi
3. Discussion
3.1. The Disease of the Four-Seeded Vetch Caused by F. proliferatum Was First Reported
3.2. Control Strategy of the Pod Disease Based on Biological Characteristics of F. proliferatum
3.3. Substance Regulation and Resistance Mechanism of Four-Seeded Vetches Under Stress
3.4. Exploring the Pathogenesis of the Pods Disease Based on Metabolomics
3.5. Analysis of Fumonisin B1 Accumulation and F. proliferatum Pathogenicity in Four-Seeded Vetches
4. Materials and Methods
4.1. Sample Collection and Strain Isolation
4.2. Pathogenicity Test
4.3. Morphological and Molecular Identification of the FVS1 Strain
4.4. Growth of FVS1 Strain in Different Media
4.5. Growth of FVS1 Strain Under Different Temperature Conditions
4.6. Growth of FVS1 Strain Under Different Light Durations
4.7. Growth of FVS1 Strain Under Different pH Conditions
4.8. Analysis of Metabolites
4.9. Screening of Biocontrol Fungi
4.10. Statistical Analysis
5. Conclusions
Author Contributions
Funding
Data Availability Statement
Acknowledgments
Conflicts of Interest
Appendix A

References
- Costa, M.M.; Sandoval-Denis, M.; Moreira, G.M.; Kandemir, H.; Kermode, A.; Buddie, A.G.; Ryan, M.J.; Becker, Y.; Yurkov, A.; Maier, W.; et al. Known from Trees and the Tropics: New Insights into the Fusarium lateritium Species Complex. Stud. Mycol. 2024, 109, 403–450. [Google Scholar] [CrossRef] [PubMed]
- Conti Taguali, S.; Riolo, M.; Dopazo, V.; Meca, G.; Cacciola, S.O. Characterization of Mycotoxins Produced by Two Fusarium Species Responsible for Postharvest Rot of Banana Fruit. J. Plant Pathol. 2024, 106, 1785–1800. [Google Scholar] [CrossRef]
- Ćeranić, A.; Svoboda, T.; Berthiller, F.; Sulyok, M.; Samson, J.M.; Güldener, U.; Schuhmacher, R.; Adam, G. Identification and Functional Characterization of the Gene Cluster Responsible for Fusaproliferin Biosynthesis in Fusarium proliferatum. Toxins 2021, 13, 468. [Google Scholar] [CrossRef]
- Yilmaz, N.; Sandoval-Denis, M.; Lombard, L.; Visagie, C.M.; Wingfield, B.D.; Crous, P.W. Redefining Species Limits in the Fusarium fujikuroi Species Complex. Persoonia 2021, 46, 129–162. [Google Scholar] [CrossRef]
- Xie, S.H.; Zhang, C.; Chen, M.S.; Wei, Z.P.; Jiang, Y.B.; Lin, X.; Zheng, Y.Q. Fusarium proliferatum: A New Pathogen Causing Fruit Rot of Peach in Ningde, China. Plant Dis. 2018, 102, 1858. [Google Scholar] [CrossRef]
- Riolo, M.; Aloi, F.; Faedda, R.; Cacciola, S.O.; Pane, A. First Report of Postharvest Fruit Rot Caused by Fusarium sacchari on Lady Finger Banana in Italy. Plant Dis. 2020, 104, 2290. [Google Scholar] [CrossRef]
- Wang, H.; Feng, D.; Chen, L.; Yang, J.; Wang, X.; Wang, J. First Report of Fusarium meridionale Causing Stalk Rot of Ryegrass in China. Plant Dis. 2022, 106, 1533. [Google Scholar] [CrossRef] [PubMed]
- Santanna, C.V.; Bradtke, J.; Dorey, J.; Burnham, R.J. Vicia tetrasperma|CLIMBERS. Available online: https://climbers.lsa.umich.edu/vicia-tetrasperma/ (accessed on 7 April 2025).
- López-Román, M.I.; De la Rosa, L.; Marcos-Prado, T.; Ramírez-Parra, E. Cross-Species Transferability of SSR Markers for Analyzing Genetic Diversity of Different Vicia Species Collections. Agronomy 2024, 14, 326. [Google Scholar] [CrossRef]
- Li, M.; Zhao, L.; Zhou, Q.; Fang, L.; Luo, D.; Liu, W.; Searle, I.R.; Liu, Z. Transcriptome and Coexpression Network Analyses Provide In-Sights into the Molecular Mechanisms of Hydrogen Cyanide Synthesis during Seed Development in Common Vetch (Vicia sativa L.). Int. J. Mol. Sci. 2022, 23, 2275. [Google Scholar] [CrossRef]
- Guo, H. Evaluation of the Feeding Value of 8 Copies of Vetch Materials in Kunming Area. Master’s Thesis, Yunnan Agricultural University, Kunming, China, 2023. [Google Scholar]
- Mikić, A. Presence of Vetches (Vicia spp.) in Agricultural and Wild Floras of Ancient Europe. Genet. Resour. Crop Evol. 2016, 63, 745–754. [Google Scholar] [CrossRef]
- Han, S.; Sebastin, R.; Wang, X.; Lee, K.J.; Cho, G.-T.; Hyun, D.Y.; Chung, J.-W. Identification of Vicia Species Native to South Korea Using Molecular and Morphological Characteristics. Front. Plant Sci. 2021, 12, 608599. [Google Scholar] [CrossRef]
- Sun, W.-H.; Wu, F.-F.; Cong, L.; Jin, M.-Y.; Wang, X.-G. Assessment of Genetic Diversity and Population Structure of the Genus Vicia (Vicia L.) Using Simple Sequence Repeat Markers. Grassl. Sci. 2022, 68, 205–213. [Google Scholar] [CrossRef]
- van de Wouw, M.; Enneking, D.; Robertson, L.D.; Maxted, N. Vetches (Vicia L.). In Plant Genetic Resources of Legumes in the Mediterranean; Maxted, N., Bennett, S.J., Eds.; Springer: Dordrecht, The Netherlands, 2001; pp. 134–158. [Google Scholar] [CrossRef]
- Dong, R.; Shen, S.H.; Jahufer, M.Z.Z.; Dong, D.K.; Luo, D.; Zhou, Q.; Chai, X.T.; Luo, K.; Nan, Z.B.; Wang, Y.R.; et al. Effect of Genotype and Environment on Agronomical Characters of Common Vetch (Vicia sativa L.). Genet. Resour. Crop Evol. 2019, 66, 1587–1599. [Google Scholar] [CrossRef]
- Sun, S.; Lui, Q.; Han, L.; Ma, Q.; He, S.; Li, X.; Zhang, H.; Zhang, J.; Liu, X.; Wang, L. Identification and Characterization of Fusarium proliferatum, a New Species of Fungi That Cause Fungal Keratitis. Sci. Rep. 2018, 8, 4859. [Google Scholar] [CrossRef] [PubMed]
- Dedecan, O.; Talapov, T.; Demral, M.; Sarpkaya, K.; Ceyhan, D.İ.; Can, C. Molecular and Pathogenic Characterization of Fusarium oxysporum and Fusarium proliferatum Causing Basal Root Rot in Garlic in Turkey. Australas. Plant Dis. Notes 2022, 17, 37. [Google Scholar] [CrossRef]
- Fathy, W.A.; Techen, N.; Elsayed, K.N.M.; Essawy, E.A.; Tawfik, E.; Alwutayd, K.M.; Abdelhameed, M.S.; Hammouda, O.; Ross, S.A. Applying an Internal Transcribed Spacer as a Single Molecular Marker to Differentiate between Tetraselmis and Chlorella Species. Front. Microbiol. 2023, 14, 1228869. [Google Scholar] [CrossRef]
- Chen, G.; Sun, J.; Cui, J.; Wang, Y.; Ran, Y.; Gong, D.; Yang, Y.; Hu, M.; Li, M. Anthracnose Caused by Colletotrichum siamense on Rambutan in China. Crop Prot. 2025, 191, 107141. [Google Scholar] [CrossRef]
- Krulj, J.; Ćurčıć, N.; Stančıć, A.B.; Kojıć, J.; Pezo, L.; Tukuljac, L.P.; Solarov, M.B. Molecular Identification and Characterisation of Aspergillus flavus Isolates Originating from Serbian Wheat Grains. Acta Aliment. 2020, 49, 382–389. [Google Scholar] [CrossRef]
- Negi, N.; Krishna, R.; Meena, R.K.; Pandey, A.; Bhandari, M.S.; Pandey, S. First Report of Lasiodiplodia iraniensis Causing Leaf Spot Disease of Eucalyptus in India. Physiol. Mol. Plant Pathol. 2023, 127, 102113. [Google Scholar] [CrossRef]
- Sunani, S.K.; Debbarma, R.; Bashyal, B.M.; Raghu, S.; Jeevan, B. First Report of Fusarium proliferatum Associated with Pod Rot of Winged Bean (Psophocarpus tetragonolobus (L.) DC.) in India. Crop Prot. 2025, 190, 107072. [Google Scholar] [CrossRef]
- Castro-Moretti, F.R.; Gentzel, I.N.; Mackey, D.; Alonso, A.P. Metabolomics as an Emerging Tool for the Study of Plant–Pathogen Interactions. Metabolites 2020, 10, 52. [Google Scholar] [CrossRef] [PubMed]
- Zhang, C.; Ou, X.; Wang, J.; Wang, Z.; Du, W.; Zhao, J.; Han, Y. Antifungal Peptide P852 Controls Fusarium Wilt in Faba Bean (Viciafaba L.) by Promoting Antioxidant Defense and Isoquinoline Alkaloid, Betaine, and Arginine Biosyntheses. Antioxidants 2022, 11, 1767. [Google Scholar] [CrossRef] [PubMed]
- Zhang, Y.; Fernie, A.R. The Role of TCA Cycle Enzymes in Plants. Adv. Biol. 2023, 7, 2200238. [Google Scholar] [CrossRef] [PubMed]
- Ferrario, M.; Pastorelli, R.; Brunelli, L.; Liu, S.; Zanella do Amaral Campos, P.P.; Casoni, D.; Z’Graggen, W.J.; Jakob, S.M. Persistent Hyperammonia and Altered Concentrations of Urea Cycle Metabolites in a 5-Day Swine Experiment of Sepsis. Sci. Rep. 2021, 11, 18430. [Google Scholar] [CrossRef]
- Wang, H.; Feng, X.; Zhang, Y.; Chen, G.; Sun, Y. Advance in study on the urea cycle related enzymes and metabolic products in plant. J. Yunnan Agric. Univ. (Nat. Sci.) 2018, 33, 334–342. [Google Scholar]
- Multari, S.; Stewart, D.; Russell, W.R. Potential of Fava Bean as Future Protein Supply to Partially Replace Meat Intake in the Human Diet. Compr. Rev. Food Sci. Food Saf. 2015, 14, 511–522. [Google Scholar] [CrossRef]
- Ibañez, S.; Medina, M.I.; Agostini, E. Vicia: A Green Bridge to Clean up Polluted Environments. Appl. Microbiol. Biotechnol. 2020, 104, 13–21. [Google Scholar] [CrossRef]
- Huang, Y.F.; Gao, X.L.; Nan, Z.B.; Zhang, Z.X. Potential Value of the Common Vetch (Vicia sativa L.) as an Animal Feedstuff: A Review. J. Anim. Physiol. Anim. Nutr. 2017, 101, 807–823. [Google Scholar] [CrossRef]
- Muthukumar, M.; Bajpai, A.; Soni, S.K.; Singh, S.K.; Bajpai, Y.; Kumar, S. Identifying the Causal Agent of Floral Malformation as Fusarium Complex Using Metagenomic and Metabolomic Approaches. Physiol. Mol. Plant Pathol. 2025, 136, 102556. [Google Scholar] [CrossRef]
- Farias, O.R.; Cruz, J.M.F.L.; Veloso, J.S.; Duarte, I.G.; Barbosa, P.R.R.; Félix, M.R.F.; Varanda, C.M.R.; Materatski, P.; Oliveira, M.D.M.; Nascimento, L.C. Occurrence of Fusarium proliferatum Causing Vascular Wilt on Cowpea (Vigna unguiculata) in Brazil. Plant Dis. 2022, 106, 1992. [Google Scholar] [CrossRef]
- Yu, X.; Zhang, J.; Guo, L.; Yu, A.; Wang, X.; Xiang, W.; Zhao, J. First Report of Fusarium proliferatum Causing Fruit Rot on Muskmelon (Cucumis melo) in China. Plant Dis. 2022, 106, 1305. [Google Scholar] [CrossRef] [PubMed]
- Li, Z.; Yu, X.; Zhang, W.; Han, R.; Zhang, J.; Ma, Y.; Guo, L.; Wang, X.; Zhao, J.; Xiang, W. Identification, Characterization, and Pathogenicity of Fungi Associated with Strawberry Fruit Rot in Shandong Province, China. Plant Dis. 2023, 107, 3773–3782. [Google Scholar] [CrossRef]
- Li, F.; Yuan, G.; Liao, T.; Li, Q.; Lin, W. Leaf Spot of Tobacco Caused by Fusarium proliferatum. J. Gen. Plant Pathol. 2017, 83, 264–267. [Google Scholar] [CrossRef]
- Zhang, X.; Yi, J.; Huo, D.; Cheng, S.; Liu, B.; Xiong, G.; Jiang, J. First Report of Fusarium proliferatum Causing Leaf Spot on Tea Plants in Jiangxi Province, China. Plant Dis. 2022, 107, 2220. [Google Scholar] [CrossRef]
- Sun, W.; Lei, T.; Yuan, H.; Chen, S. Occurrence of Root Rot Caused by Fusarium fujikuroi and Fusarium proliferatum on Peanut in China. Plant Dis. 2022, 107, 940. [Google Scholar] [CrossRef] [PubMed]
- Chen, H.; Xue, L.H.; Li, C.J. First Report of Oat (Avena sativa) Root Rot Caused by Fusarium proliferatum in China. Plant Dis. 2020, 104, 993. [Google Scholar] [CrossRef]
- Eğerci, Y.; Kınay-Teksür, P.; Uysal-Morca, A. First Report of Bakanae Disease Caused by Fusarium proliferatum on Rice in Turkey. J. Plant Dis. Prot. 2021, 128, 577–582. [Google Scholar] [CrossRef]
- Yu, H.; Hwang, S.-F.; Strelkov, S.E. The Host Range of Fusarium proliferatum in Western Canada. Pathogens 2024, 13, 407. [Google Scholar] [CrossRef]
- Ha, M.S.; Ryu, H.; Ju, H.J.; Choi, H.-W. Diversity and Pathogenic Characteristics of the Fusarium Species Isolated from Minor Legumes in Korea. Sci. Rep. 2023, 13, 22516. [Google Scholar] [CrossRef]
- Naeem, M.; Li, H.; Yan, L.; Raza, M.A.; Gong, G.; Chen, H.; Yang, C.; Zhang, M.; Shang, J.; Liu, T.; et al. Characterization and Pathogenicity of Fusarium Species Associated with Soybean Pods in Maize/Soybean Strip Intercropping. Pathogens 2019, 8, 245. [Google Scholar] [CrossRef]
- Beccari, G.; Hao, G.; Liu, H. Editorial: Fusarium Pathogenesis: Infection Mechanisms and Disease Progression in Host Plants. Front. Plant Sci. 2022, 13, 1020404. [Google Scholar] [CrossRef]
- Lahlali, R.; Taoussi, M.; Laasli, S.-E.; Gachara, G.; Ezzouggari, R.; Belabess, Z.; Aberkani, K.; Assouguem, A.; Meddich, A.; El Jarroudi, M.; et al. Effects of Climate Change on Plant Pathogens and Host-Pathogen Interactions. Crop Environ. 2024, 3, 159–170. [Google Scholar] [CrossRef]
- Punja, Z.K. First Report of Fusarium proliferatum Causing Crown and Stem Rot, and Pith Necrosis, in Cannabis (Cannabis sativa L., Marijuana) Plants. Can. J. Plant Pathol. 2021, 43, 236–255. [Google Scholar] [CrossRef]
- Fanelli, F.; Schmidt-Heydt, M.; Haidukowski, M.; Geisen, R.; Logrieco, A.; Mulè, G. Influence of Light on Growth, fumonisin Biosynthesis and FUM1 Gene Expression by Fusarium proliferatum. Int. J. Food Microbiol. 2012, 153, 148–153. [Google Scholar] [CrossRef] [PubMed]
- Manickam, S.; Rajagopalan, V.R.; Kambale, R.; Rajasekaran, R.; Kanagarajan, S.; Muthurajan, R. Plant Metabolomics: Current Initiatives and Future Prospects. Curr. Issues Mol. Biol. 2023, 45, 8894–8906. [Google Scholar] [CrossRef] [PubMed]
- Bao, L.; Gao, H.; Zheng, Z.; Zhao, X.; Zhang, M.; Jiao, F.; Su, C.; Qian, Y. Integrated Transcriptomic and Un-Targeted Metabolomics Analysis Reveals Mulberry Fruit (Morus atropurpurea) in Response to Sclerotiniose Pathogen Ciboria shiraiana Infection. Int. J. Mol. Sci. 2020, 21, 1789. [Google Scholar] [CrossRef] [PubMed]
- Trovato, M.; Funck, D.; Forlani, G.; Okumoto, S.; Amir, R. Editorial: Amino Acids in Plants: Regulation and Functions in Development and Stress Defense. Front. Plant Sci. 2021, 12, 772810. [Google Scholar] [CrossRef]
- Ji, H.; Yang, G.; Zhang, X.; Zhong, Q.; Qi, Y.; Wu, K.; Shen, T. Regulation of Salt Tolerance in the Roots of Zea mays by L-Histidine through Transcriptome Analysis. Front. Plant Sci. 2022, 13, 1049954. [Google Scholar] [CrossRef]
- Sadak, M.S.; Sekara, A.; Al-Ashkar, I.; Habib-Ur-Rahman, M.; Skalicky, M.; Brestic, M.; Kumar, A.; Sabagh, A.E.; Abdelhamid, M.T. Exogenous Aspartic Acid Alleviates Salt Stress-Induced Decline in Growth by Enhancing Antioxidants and Compatible Solutes While Reducing Reactive Oxygen Species in Wheat. Front. Plant Sci. 2022, 13, 987641. [Google Scholar] [CrossRef]
- Han, M.; Wang, S.; Wu, L.; Feng, J.; Si, Y.; Liu, X.; Su, T. Effects of Exogenous L-Asparagine on Poplar Biomass Partitioning and Root Morphology. Int. J. Mol. Sci. 2022, 23, 13126. [Google Scholar] [CrossRef]
- Han, M.; Zhang, C.; Suglo, P.; Sun, S.; Wang, M.; Su, T. L-Aspartate: An Essential Metabolite for Plant Growth and Stress Acclimation. Molecules 2021, 26, 1887. [Google Scholar] [CrossRef] [PubMed]
- Luo, W.; Xu, J.; Chen, H.; Zhang, H.; Yang, P.; Yu, X. Synthesis of L-Asparagine Catalyzed by a Novel Asparagine Synthase Coupled with an ATP Regeneration System. Front. Bioeng. Biotechnol. 2021, 9, 747404. [Google Scholar] [CrossRef]
- Gazi, S.; Göncüoğlu Taş, N.; Görgülü, A.; Gökmen, V. Effectiveness of Asparaginase on Reducing Acrylamide Formation in Bakery Products According to Their Dough Type and Properties. Food Chem. 2023, 402, 134224. [Google Scholar] [CrossRef] [PubMed]
- Henschel, J.M.; de Andrade, A.N.; dos Santos, J.B.L.; da Silva, R.R.; da Mata, D.A.; Souza, T.; Batista, D.S. Lipidomics in Plants Under Abiotic Stress Conditions: An Overview. Agronomy 2024, 14, 1670. [Google Scholar] [CrossRef]
- Chen, S.; Inui, S.; Aisyah, R.; Nakashima, R.; Kawaguchi, T.; Hinomoto, M.; Nakagawa, Y.; Sakuma, T.; Sotomaru, Y.; Ohshima, N.; et al. Role of Gpcpd1 in Intestinal Alpha-Glycerophosphocholine Metabolism and Trimethylamine N-Oxide Production. J. Biol. Chem. 2024, 300, 107965. [Google Scholar] [CrossRef]
- Kwon, Y.; Yu, S.-I.; Lee, H.; Yim, J.H.; Zhu, J.-K.; Lee, B.-H. Arabidopsis Serine Decarboxylase Mutants Implicate the Roles of Ethanolamine in Plant Growth and Development. Int. J. Mol. Sci. 2012, 13, 3176–3188. [Google Scholar] [CrossRef]
- van der Rest, B.; Boisson, A.-M.; Gout, E.; Bligny, R.; Douce, R. Glycerophosphocholine Metabolism in Higher Plant Cells. Evidence of a New Glyceryl-Phosphodiester Phosphodiesterase. Plant Physiol. 2002, 130, 244–255. [Google Scholar] [CrossRef]
- Mizoi, J.; Nakamura, M.; Nishida, I. A Study of the Physiological Function of Phosphatidylethanolamine in Arabidopsis. In Advanced Research on Plant Lipids: Proceedings of the 15th International Symposium on Plant Lipids, Okazaki, Japan, 12–17 May 2002; Murata, N., Yamada, M., Nishida, I., Okuyama, H., Sekiya, J., Hajime, W., Eds.; Springer: Dordrecht, The Netherlands, 2003; pp. 377–380. [Google Scholar] [CrossRef]
- Rajaeian, S.; Ehsanpour, A.A.; Javadi, M.; Shojaee, B. Ethanolamine Induced Modification in Glycine Betaine and Proline Metabolism in Nicotiana rustica under Salt Stress. Biol. Plant 2017, 61, 797–800. [Google Scholar] [CrossRef]
- Zhang, K.; Lyu, W.; Gao, Y.; Zhang, X.; Sun, Y.; Huang, B. Choline-Mediated Lipid Reprogramming as a Dominant Salt Tolerance Mechanism in Grass Species Lacking Glycine Betaine. Plant Cell Physiol. 2021, 61, 2018–2030. [Google Scholar] [CrossRef]
- Bare, A.; Thomas, J.; Etoroma, D.; Lee, S.G. Functional Analysis of Phosphoethanolamine N-Methyltransferase in Plants and Parasites: Essential S-Adenosylmethionine-Dependent Methyltransferase in Choline and Phospholipid Metabolism. In Methods in Enzymology; Elsevier: Amsterdam, The Netherlands, 2023; Volume 680, pp. 101–137. [Google Scholar] [CrossRef]
- Dias, M.C.; Pinto, D.C.G.A.; Silva, A.M.S. Plant Flavonoids: Chemical Characteristics and Biological Activity. Molecules 2021, 26, 5377. [Google Scholar] [CrossRef]
- Shi, H.; Jiang, J.; Yu, W.; Cheng, Y.; Wu, S.; Zong, H.; Wang, X.; Ding, A.; Wang, W.; Sun, Y. Naringenin Restricts the Colonization and Growth of Ralstonia solanacearum in Tobacco Mutant KCB-1. Plant Physiol. 2024, 195, 1818–1834. [Google Scholar] [CrossRef] [PubMed]
- Zeng, J.; Chen, C.; Chen, M.; Chen, J. Comparative Transcriptomic and Metabolomic Analyses Reveal the Delaying Effect of Naringin on Postharvest Decay in Citrus Fruit. Front. Plant Sci. 2022, 13, 1045857. [Google Scholar] [CrossRef] [PubMed]
- Li, X.; Zhang, J.; Lin, S.; Xing, Y.; Zhang, X.; Ye, M.; Chang, Y.; Guo, H.; Sun, X. (+)-Catechin, Epicatechin and Epigallocatechin Gallate Are Important Inducible Defensive Compounds against Ectropis grisescens in Tea Plants. Plant Cell Environ. 2022, 45, 496–511. [Google Scholar] [CrossRef]
- Goupil, P.; Peghaire, E.; Benouaret, R.; Richard, C.; Sleiman, M.; El Alaoui, H.; Kocer, A. Relationships between Plant Defense Inducer Activities and Molecular Structure of Gallomolecules. J. Agric. Food Chem. 2020, 68, 15409–15417. [Google Scholar] [CrossRef] [PubMed]
- Dong, X.; Li, W.; Li, C.; Akan, O.D.; Liao, C.; Cao, J.; Zhang, L. Integrated Transcriptomics and Metabolomics Revealed the Mechanism of Catechin Biosynthesis in Response to Lead Stress in Tung Tree (Vernicia fordii). Sci. Total Environ. 2024, 930, 172796. [Google Scholar] [CrossRef]
- Guo, Y.; Lv, J.; Zhao, Q.; Dong, Y.; Dong, K. Cinnamic Acid Increased the Incidence of Fusarium Wilt by Increasing the Pathogenicity of Fusarium oxysporum and Reducing the Physiological and Biochemical Resistance of Faba Bean, Which Was Alleviated by Intercropping With Wheat. Front. Plant Sci. 2020, 11, 608389. [Google Scholar] [CrossRef]
- Kapoor, R.T.; Alyemeni, M.N.; Ahmad, P. Exogenously Applied Spermidine Confers Protection against Cinnamic Acid-Mediated Oxidative Stress in Pisum sativum. Saudi J. Biol. Sci. 2021, 28, 2619–2625. [Google Scholar] [CrossRef]
- Zhukov, A.V. Palmitic Acid and Its Role in the Structure and Functions of Plant Cell Membranes. Russ. J. Plant Physiol. 2015, 62, 706–713. [Google Scholar] [CrossRef]
- Ma, K.; Kou, J.; Khashi U Rahman, M.; Du, W.; Liang, X.; Wu, F.; Li, W.; Pan, K. Palmitic Acid Mediated Change of Rhizosphere and Alleviation of Fusarium Wilt Disease in Watermelon. Saudi J. Biol. Sci. 2021, 28, 3616–3623. [Google Scholar] [CrossRef]
- Sunic, K.; D’Auria, J.C.; Sarkanj, B.; Spanic, V. Metabolic Profiling Identifies Changes in the Winter Wheat Grains Following Fusarium Treatment at Two Locations in Croatia. Plants 2023, 12, 911. [Google Scholar] [CrossRef]
- Fei, Y.-C.; Cheng, Q.; Zhang, H.; Han, C.; Wang, X.; Li, Y.-F.; Li, S.-Q.; Zhao, X.-H. Maleic Acid and Malonic Acid Reduced the Pathogenicity of Sclerotinia sclerotiorum by Inhibiting Mycelial Growth, Sclerotia Formation and Virulence Factors. Stress Biol. 2023, 3, 45. [Google Scholar] [CrossRef] [PubMed]
- Li, Y.; Chen, P.; Fu, Z.; Luo, K.; Du, Q.; Gao, C.; Ren, J.; Yang, X.; Liu, S.; Yang, L.; et al. Research progress on regulation of root nodule formation and development of legume by light signals and photosynthetic products. Chin. J. Eco-Agric. 2023, 31, 21–30. [Google Scholar]
- Dias, M.C.; Pinto, D.C.G.A.; Costa, M.; Araújo, M.; Santos, C.; Silva, A.M.S. Phytochemical and Antioxidant Profile of the Medicinal Plant Melia azedarach Subjected to Water Deficit Conditions. Int. J. Mol. Sci. 2022, 23, 13611. [Google Scholar] [CrossRef]
- Ramzan, M.; Haider, S.T.A.; Hussain, M.B.; Ehsan, A.; Datta, R.; Alahmadi, T.A.; Ansari, M.J.; Alharbi, S.A. Potential of Kaempferol and Caffeic Acid to Mitigate Salinity Stress and Improving Potato Growth. Sci. Rep. 2024, 14, 21657. [Google Scholar] [CrossRef]
- Frenț, O.-D.; Stefan, L.; Morgovan, C.M.; Duteanu, N.; Dejeu, I.L.; Marian, E.; Vicaș, L.; Manole, F. A Systematic Review: Quercetin-Secondary Metabolite of the Flavonol Class, with Multiple Health Benefits and Low Bioavailability. Int. J. Mol. Sci. 2024, 25, 12091. [Google Scholar] [CrossRef]
- Singh, P.; Arif, Y.; Bajguz, A.; Hayat, S. The Role of Quercetin in Plants. Plant Physiol. Biochem. 2021, 166, 10–19. [Google Scholar] [CrossRef]
- Luo, S.; Wang, Y.; Cui, B.; Xu, Z.; Jiao, Y.; Cheng, Y. Research progress on separation and purification of flavonoids by nano-solid-phase extractant. Food Mach. 2022, 38, 202–209. [Google Scholar]
- Raza, A.; Zahra, N.; Hafeez, M.B.; Ahmad, M.; Iqbal, S.; Shaukat, K.; Ahmad, G. Nitrogen Fixation of Legumes: Biology and Physiology. In The Plant Family Fabaceae: Biology and Physiological Responses to Environmental Stresses; Hasanuzzaman, M., Araújo, S., Gill, S.S., Eds.; Springer: Singapore, 2020; pp. 43–74. [Google Scholar] [CrossRef]
- Patil, J.R.; Mhatre, K.J.; Yadav, K.; Yadav, L.S.; Srivastava, S.; Nikalje, G.C. Flavonoids in Plant-Environment Interactions and Stress Responses. Discov. Plants 2024, 1, 68. [Google Scholar] [CrossRef]
- Wang, L.; Liu, Q.; Ge, S.; Liang, W.; Liao, W.; Li, W.; Jiao, G.; Wei, X.; Shao, G.; Xie, L.; et al. Genomic Footprints Related with Adaptation and fumonisins Production in Fusarium proliferatum. Front. Microbiol. 2022, 13, 1004454. [Google Scholar] [CrossRef]
- Phan, L.T.K.; Le, A.T.H.; Hoang, N.T.N.; Debonne, E.; De Saeger, S.; Eeckhout, M.; Jacxsens, L. Evaluation of the Efficacy of Cinnamon Oil on Aspergillus flavus and Fusarium proliferatum Growth and Mycotoxin Production on Paddy and Polished Rice: Towards a Mitigation Strategy. Int. J. Food Microbiol. 2024, 415, 110636. [Google Scholar] [CrossRef]
- Noorabadi, M.T.; Masiello, M.; Taherkhani, K.; Zare, R.; Torbati, M.; Haidukowski, M.; Somma, S.; Logrieco, A.F.; Moretti, A.; Susca, A. Phylogeny and Mycotoxin Profile of Fusarium Species Isolated from Sugarcane in Southern Iran. Microbiol. Res. 2021, 252, 126855. [Google Scholar] [CrossRef]
- Xie, L.; Wu, Y.; Wang, Y.; Jiang, Y.; Yang, B.; Duan, X.; Li, T. Fumonisin B1 Induced Aggressiveness and Infection Mechanism of Fusarium proliferatum on Banana Fruit. Environ. Pollut. 2021, 288, 117793. [Google Scholar] [CrossRef]
- Covarelli, L.; Stifano, S.; Beccari, G.; Raggi, L.; Lattanzio, V.M.T.; Albertini, E. Characterization of Fusarium verticillioides Strains Isolated from Maize in Italy: Fumonisin Production, Pathogenicity and Genetic Variability. Food Microbiol. 2012, 31, 17–24. [Google Scholar] [CrossRef] [PubMed]
- Haapalainen, M.; Kuivainen, E.; Iivonen, S.; Niemi, M.; Latvala, S. Pathogenicity of Fusarium oxysporum and Fusarium proliferatum Isolates from Symptomless Onions (Allium cepa) and Onions with Fusarium Basal Rot. Plant Pathol. 2023, 72, 1122–1135. [Google Scholar] [CrossRef]
- Chen, J.; Wei, Z.; Wang, Y.; Long, M.; Wu, W.; Kuca, K. Fumonisin B1: Mechanisms of Toxicity and Biological Detoxification Progress in Animals. Food Chem. Toxicol. 2021, 149, 111977. [Google Scholar] [CrossRef] [PubMed]
- Lei, S.; Wang, L.; Liu, L.; Hou, Y.; Xu, Y.; Liang, M.; Gao, J.; Li, Q.; Huang, S. Infection and Colonization of Pathogenic Fungus Fusarium proliferatum in Rice Spikelet Rot Disease. Rice Sci. 2019, 26, 60–68. [Google Scholar] [CrossRef]
- Gao, Z.; Luo, K.; Zhu, Q.; Peng, J.; Liu, C.; Wang, X.; Li, S.; Zhang, H. The Natural Occurrence, Toxicity Mechanisms and Management Strategies of Fumonisin B1: A Review. Environ. Pollut. 2023, 320, 121065. [Google Scholar] [CrossRef]
- Lanubile, A.; Bellin, D.; Ottaviani, L.; Jaberi, M.; Marocco, A.; Mulè, G.; Paciolla, C. Effect of Fumonisin B1 on Transcriptional Profiles and Biochemical Signatures in Resistant and Susceptible Maize Shoots. J. Plant Growth Regul. 2024. [Google Scholar] [CrossRef]
- Iqbal, N.; Czékus, Z.; Poór, P.; Ördög, A. Plant Defence Mechanisms against Mycotoxin Fumonisin B1. Chem. Biol. Interact. 2021, 343, 109494. [Google Scholar] [CrossRef]
- Li, X.; Fu, H. Fungal Spore Aerosolization at Different Positions of a Growing Colony Blown by Airflow. Aerosol Air Qual. Res. 2020, 20, 2826–2833. [Google Scholar] [CrossRef]
- Fu, R.; Chen, C.; Wang, J.; Liu, Y.; Zhao, L.; Lu, D. Diversity Analysis of the Rice False Smut Pathogen Ustilaginoidea virens in Southwest China. J. Fungi 2022, 8, 1204. [Google Scholar] [CrossRef] [PubMed]
- Li, J.; Xu, J.; Wang, H.; Wu, C.; Zheng, J.; Zhang, C.; Han, Y. First Report of Fungal Pathogens Causing Leaf Spot on Sorghum-Sudangrass Hybrids and Their Interactions with Plants. Plants 2023, 12, 3091. [Google Scholar] [CrossRef] [PubMed]
- Xu, J.; Li, J.; Wang, H.; Liu, X.; Gao, Z.; Chen, J.; Han, Y. Metabolic and Antioxidant Responses of Different Control Methods to the Interaction of Sorghum sudangrass hybrids-Colletotrichum boninense. Int. J. Mol. Sci. 2024, 25, 9505. [Google Scholar] [CrossRef] [PubMed]
- Liao, X.; Hou, W.; Tang, X.; Zhao, Y. Identification of the Roselle Root Rot Pathogen and Its Sensitivity to Different Fungicides. Arab. J. Chem. 2022, 15, 103932. [Google Scholar] [CrossRef]







| Species | Accession Number 1,2,3 | Locality | Substrate | GenBank Accession Numbers 4 | |
|---|---|---|---|---|---|
| TUB2 | TEF1 | ||||
| F. proliferatum | - | Malaysia | Hylocereus polyrhizus | JX868893 | JX868976 |
| F. proliferatum | NRRL 66417 | USA | Vitis vinifera | MH398182 | KX656215 |
| F. proliferatum | NRRL 66451 | USA | V. vinifera | MH398240 | KX656221 |
| F. anthophilum | CBS 136.95 | Netherlands | Amaryllis | MW402257 | MW402058 |
| F. fujikuroi | CBS 240.64 | Japan | Oryza sativa | MW402315 | MW402117 |
| F. verticillioides | CBS 139.40 | Italy | Phyllocactus hybridus | MW402263 | MW402064 |
| F. concentricum | CBS 453.97 | Guatemala | Musa sapientum | MN534123 | MN533998 |
| F. ananatum | CMW 28599 | South Africa | Ananas comosus | MW402358 | MW402157 |
| F. globosum | CBS 120992 | South Africa | Maize kernels | MW402198 | MW401998 |
| F. madaense | CBS 146651 | Nigeria | Sorghum | MW402295 | MW402096 |
| F. sterilihyposum | NRRL 53991 | Brazil | Mangifera indica | GU737305 | GU737413 |
| F. sacchari | CBS 183.32 | - | Saccharum officinarum | MW402302 | MW402104 |
| F. nygamai | CBS 120995 | Australia | Sorghum root | MW402199 | MW401999 |
| F. tupiense | NRRL 53996 | Brazil | Mangifera indica | DQ445782 | DQ452860 |
| F. lactis | CBS 420.97 | USA | Ficus carica | MN534078 | MN534015 |
| F.pseudonygamai | CBS 416.97 | Nigeria | Pennisetum typhoides | MN534064 | MN534030 |
| Item | Treatments | FVS1 |
|---|---|---|
| Different media | PDA | 6.865 ± 0.107 a |
| SCDA | 6.157 ± 0.135 c | |
| PSA | 6.734 ± 0.079 ab | |
| MEA | 6.554 ± 0.222 b | |
| OA | 6.769 ± 0.096 ab | |
| Different temperature (℃) | 5 | - |
| 10 | - | |
| 15 | 6.037 ± 0.252 b | |
| 20 | 6.278 ± 0.165 ab | |
| 25 | 6.518 ± 0.165 a | |
| 30 | 6.458 ± 0.135 a | |
| 35 | - | |
| Different light durations (h) | 0 h/24 | 6.614 ± 0.210 a |
| 24 h/0 | 6.649 ± 0.240 a | |
| 12 h/12 | 6.579 ± 0.165 a | |
| Different pH | 5 | 6.950 ± 0.068 ab |
| 7 | 7.070 ± 0.096 a | |
| 9 | 6.830 ± 0.130 b | |
| 11 | 6.278 ± 0.165 c |
| Gene 1 | Primers | Sequence (5′-3′) | References |
|---|---|---|---|
| ITS | ITS1 | TCCGTAGGTGAACCTGCGG | [19] |
| ITS4 | TCCTCCGCTTATTGATATGC | ||
| ACT | ACT512F | ATGTGCAAGGCCGGTTTCGC | [20] |
| ACT783R | TACGAGTCCTTCTGGCCCAT | ||
| Tub | BT-2a | GGTAACCAAATCGGTGCTGCTTTC | [21] |
| BT-2b | ACCCTCAGTGTAGTGACCCTTGGC | ||
| Tef | EF1-728F | CATCGAGAAGTTCGAGAAGG | [22,23] |
| EF-2 | GGARGTACCAGTSATCATGTT |
Disclaimer/Publisher’s Note: The statements, opinions and data contained in all publications are solely those of the individual author(s) and contributor(s) and not of MDPI and/or the editor(s). MDPI and/or the editor(s) disclaim responsibility for any injury to people or property resulting from any ideas, methods, instructions or products referred to in the content. |
© 2025 by the authors. Licensee MDPI, Basel, Switzerland. This article is an open access article distributed under the terms and conditions of the Creative Commons Attribution (CC BY) license (https://creativecommons.org/licenses/by/4.0/).
Share and Cite
Shi, K.; Xu, J.; Wang, H.; Xue, X.; Xie, Z.; Han, Y. First Report of Fusarium proliferatum Infection in Pods of Four-Seeded Vetch and Its Relationships with Plants. Plants 2025, 14, 1480. https://doi.org/10.3390/plants14101480
Shi K, Xu J, Wang H, Xue X, Xie Z, Han Y. First Report of Fusarium proliferatum Infection in Pods of Four-Seeded Vetch and Its Relationships with Plants. Plants. 2025; 14(10):1480. https://doi.org/10.3390/plants14101480
Chicago/Turabian StyleShi, Kexin, Jingxuan Xu, Hongji Wang, Xiaoliang Xue, Zihan Xie, and Yuzhu Han. 2025. "First Report of Fusarium proliferatum Infection in Pods of Four-Seeded Vetch and Its Relationships with Plants" Plants 14, no. 10: 1480. https://doi.org/10.3390/plants14101480
APA StyleShi, K., Xu, J., Wang, H., Xue, X., Xie, Z., & Han, Y. (2025). First Report of Fusarium proliferatum Infection in Pods of Four-Seeded Vetch and Its Relationships with Plants. Plants, 14(10), 1480. https://doi.org/10.3390/plants14101480

